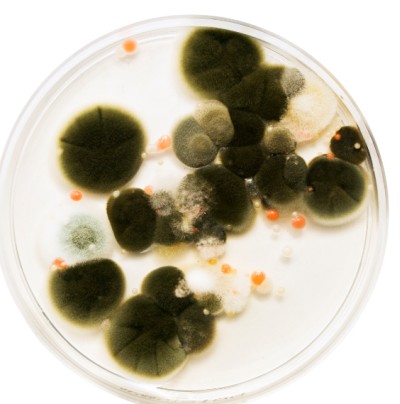
parabeny3

Na opakowaniach produktów kosmetycznych pojawiły się napisy 0% parabenów albo paraben free. Czy wobec tego są one szkodliwe i należy ich unikać choć latami stosowane były przez firmy farmaceutyczne, kosmetyczne oraz producentów żywności? Produkt wolny od parabenów nadal ma długą datę ważności, czym zatem tego został zakonserwowany? Ekstraktem roślinnym czy może chemią pod inną nazwą?
Na opakowaniach produktów kosmetycznych pojawiły się napisy 0% parabenów albo paraben free. Czy wobec tego są one szkodliwe i należy ich unikać choć latami stosowane były przez firmy farmaceutyczne, kosmetyczne oraz producentów żywności? Produkt wolny od parabenów nadal ma długą datę ważności, czym zatem tego został zakonserwowany? Ekstraktem roślinnym czy może chemią pod inną nazwą?
Jak nie wiadomo o co chodzi…
Produkt kosmetyczny bez konserwantów może być niebezpieczny dla naszego zdrowia. Czynnikami wpływającymi na odporność kosmetyku na zakażenie są m. in. struktura fizyczna, zawartość i jakość wody, ilość substancji stanowiących pożywkę dla drobnoustrojów, typ opakowania, odczyn pH oraz zawartość inhibitorów. - Konserwanty mają chronić kosmetyk przed zepsuciem. Hamując rozwój drobnoustrojów wszystkich mikroorganizmów zabezpieczają produkt kosmetyczny. Użycie zepsutego kosmetyku bądź kosmetyku z mikroorganizmami może wyrządzić dużą szkodę naszemu zdrowiu – wyjaśnia Dorota Rożek z Laboratorium Badań Wyrobów Kosmetycznych i Chemii Gospodarczej „IZIS”.
Parabeny to substancje chemiczne o podobnej budowie molekularnej. W kosmetologii stosuje się najczęściej:
-
etyloparaben
-
butyloparaben
-
metyloparaben
-
propyloparaben
Wszystkie konserwanty dopuszczone do stosowania w produktach kosmetycznych opisuje Wykaz substancji konserwujących dozwolonych w produktach kosmetycznych, czyli załącznik V do Rozporządzenia Parlamentu Europejskiego i Rady (WE) NR 1223/2009 z 30 listopada 2009 r. W dokumencie podane są również maksymalne stężenia wszystkich dopuszczonych konserwantów. Kwas 4-hydroksybenzoesowy oraz jego sole i estry (czyli parabeny – przyp. red.) znajdują się na 12. miejscu w wykazie. Specjaliści są zgodni mówiąc, że idealny konserwant powinien być przede wszystkim skuteczny wobec wszelkiego spektrum mikroorganizmów oraz nietoksyczny dla skóry w dawkach dopuszczonych przez odpowiednie regulacje. Ważne jest, aby nie powodował alergii, nie ulatniał się z receptury, a przy tym wykazywał dużą skuteczność w szerokim zakresie pH .
- Uważam, że najlepszymi konserwantami, dostępnym na rynku są parabeny, które ostatnio mają bardzo złą opinię. Opisując negatywne działanie konserwantów, nie myślimy o tym, że codziennie pochłaniamy je w lekach, w serkach, w dżemach. Parabeny są wszędzie. Zabezpieczają masę przed bakteriami gram +, gram -, przed pleśniami i grzybami – przekonuje dr Agnieszka Przeździecka, kierownik laboratorium Vipera Cosmetics.
40% konsumentów zwraca uwagę na to, czy produkt kosmetyczny jest wolny od parabenów. Taki ruch wymusza na firmach rynek.
- Na prośbę naszych klientów z części serii wycofaliśmy parabeny i zastąpiliśmy je euxylem, to jest połączeniem fenyloetanolu i ethylhexyl glicerolu. Odpowiedzieliśmy na potrzeby rynku, sami z siebie nie odeszlibyśmy od parabenów – przyznaje Monika Krzyżostan, technolog Laboratorium Kosmetycznego AVA.
 Poza brakiem jednoznacznych wyników badań, wskazujących na jakikolwiek szkodliwy wpływ parabenów na zdrowie człowieka, technologowie podkreślają jego właściwości dla spójności kosmetyków. Niektóre konserwanty bardzo rozrzedzają masę, z reguły dodaje się je na koniec recepturowania, po dodaniu składników aktywnych w temperaturze pokojowej. Parabeny nie mają wpływu na konsystencję, tak więc z technologicznego punktu widzenia są łatwe we wprowadzaniu do receptur. Jednak z biznesowej strony, warto było wykreować kosmetyczną burzę, która na pewno zapewniła branży niemałe profity. Scientific Committee on Consumer Safety (SCCS) wydał opinię na temat analizowanych konserwantów. Stwierdzono, że zastosowanie maksymalnego dopuszczonego stężenia methylparabenu i ethylparabenu uznaje się za bezpieczne. Poza tym, wykorzystywanie butylparabenu i propylparabenu w finalnym wyrobie kosmetycznym jest niegroźne dla konsumenta w koncentracji 0,19%. Wnioski zostały wyciągnięte w oparciu o badania wykonywane na szczurach. Wykazano brak danych naukowych decydujących o zależności pomiędzy wchłanianiem przez skórę zwierzęcia i człowieka, ze szczególnym uwzględnieniem metabolizmu macierzystego związku chemicznego w skórze.
Poza brakiem jednoznacznych wyników badań, wskazujących na jakikolwiek szkodliwy wpływ parabenów na zdrowie człowieka, technologowie podkreślają jego właściwości dla spójności kosmetyków. Niektóre konserwanty bardzo rozrzedzają masę, z reguły dodaje się je na koniec recepturowania, po dodaniu składników aktywnych w temperaturze pokojowej. Parabeny nie mają wpływu na konsystencję, tak więc z technologicznego punktu widzenia są łatwe we wprowadzaniu do receptur. Jednak z biznesowej strony, warto było wykreować kosmetyczną burzę, która na pewno zapewniła branży niemałe profity. Scientific Committee on Consumer Safety (SCCS) wydał opinię na temat analizowanych konserwantów. Stwierdzono, że zastosowanie maksymalnego dopuszczonego stężenia methylparabenu i ethylparabenu uznaje się za bezpieczne. Poza tym, wykorzystywanie butylparabenu i propylparabenu w finalnym wyrobie kosmetycznym jest niegroźne dla konsumenta w koncentracji 0,19%. Wnioski zostały wyciągnięte w oparciu o badania wykonywane na szczurach. Wykazano brak danych naukowych decydujących o zależności pomiędzy wchłanianiem przez skórę zwierzęcia i człowieka, ze szczególnym uwzględnieniem metabolizmu macierzystego związku chemicznego w skórze.
Piękna i bestie, czyli bajkowa symbioza
Masy kolorowe w większości oparte są na układach całkowicie bezwodnych. Szminki na przykład bazują na woskach oraz olejach. Produkty te, z punktu widzenia konserwacji, pozornie nie powinny być zabezpieczane, bo tam nie ma co się zepsuć. Mimo wszystko największy błąd jaki mogą popełnić producenci to zbagatelizowanie potrzeby ochronienia produktu przed zepsuciem.
Szminki mają bezpośredni kontakt z ustami. Dotykając ust w jakiś sposób cały czas ją „zakażamy”. Ponadto w szmince znajdują się oleje, które mają to do siebie, że jełczeją, więc podstawową zasadą jest dodanie antyoksydantu np. wit E.
- Pamiętajmy, że najważniejsze to zabezpieczyć substancje oleiste! Większość z nich ma wiązania podwójne, a one bardzo łatwo ulegają utlenianiu. Podobnie jest z błyszczykami. Są to masy, które nie mają wody i mogłoby się wydawać, że w związku z tym nie muszą być zakonserwowane, bo to środowisko wodne jest źródłem większości bakterii. Ale aplikator dotyka ust, a potem wkładany jest do pojemnika z kosmetykiem i tak wielokrotnie wprowadza się drobnoustroje do kosmetyku – wyjaśnia dr Agnieszka Przeździecka.
W szminkach i pomadkach znajdują się pigmenty, które stanowią niewdzięczny surowiec w kosmetyce kolorowej. Dr Przeździecka przyznaje, że kiedyś szminki opierały się na pigmentach sypkich i wiele firm nadal je stosuje. Najpierw uciera się te pigmenty, np. w oleju rycynowym i otrzymuje się masę, tzw. rozcierkę. Następnie należy użyć trójwalcówki, w celu efektywnego utarcia pigmentów.
- My kupujemy gotowe dyspersje, czyli zdyspergowane pigmenty, o jednolitej masie. One również bazują na oleju rycynowym, więc zabezpieczamy je przed utlenianiem, ale poza tym wszystkie pigmenty są zazwyczaj hydrofilowe, czyli mają duże powinowactwo do wody oraz charakteryzuje je higroskopijność, czyli zdolność wchłaniania wody – tłumaczy technolog .
Kierownik laboratorium Vipera Cosmetics zwraca uwagę, że wszystkie wypełniacze tj. talki i kaoliny, na których opierają się produkty prasowane (pudry, cienie, róże) łatwo chłoną wodę, więc stają się środowiskiem zakażonym, przyjaznym dla rozwoju drobnoustrojów, pleśni i grzybów. Co więcej, stosując nośniki typu pędzel czy gąbka dodatkowo zanieczyszczamy produkt.
Wyobraźmy sobie zwyczajny krem na noc, który codziennie stosujemy, wkładając do pojemnika palec, a następnie nakładając produkt na skórę. Przez cały czas wprowadzamy do niego drobnoustroje, które znajdują się na naszej skórze. I w ten sposób „zakażamy” kosmetyk .
Z zakonserwowaniem produktów sypkich większych problemów nie ma. Dr Przeździecka nie stosuje w nich parabenów tylko fenoxyetanol i caprylic glikol. Przyznaje natomiast, że trudniejsza sytuacja pojawia się w przypadku emulsji, czyli układu łączącego fazę olejową z wodną, z pigmentami i filtrami przeciwsłonecznymi.
– Jeżeli chodzi o tego typu produkty, decydujemy się na wykonanie koko testów. Polegają one na sześciokrotnym zakażeniu emulsji i cotygodniowym odczytywaniu wyniku. Jeżeli po 6 tygodniach nic złego nie dzieje się z kosmetykiem, to test jest pozytywny, a produkt może stać na pólkach sklepowych do 30 miesięcy – wyjaśnia.
Bezpieczeństwo przede wszystkim
Rozumiejąc potrzebę zakonserwowania produktu kosmetycznego, tak jak chroni się jedzenie przed zepsuciem, nasuwa się pytanie czy konsument może wpłynąć na jakość, trwałość i świeżość artykułów.
kosmetycznych? Co zrobić, aby nie straciły na swoich właściwościach i działaniu? Większa część odpowiedzialności za powyższe wartości spoczywa na producentach i ich technologach. My, nabywcy wymagamy, aby kosmetyki pięknie pachniały, miały długą datę ważności, przyjemną konsystencję i kolor.
 - Oczywiście wykonuje się testy konserwacji, czyli badania skuteczności zakonserwowania kosmetyku. Jest to znaczący zabieg, ale dużo zależy od konsumenta i tego jak on ten kosmetyk użytkuje – zaznacza Dorota Rożek.
- Oczywiście wykonuje się testy konserwacji, czyli badania skuteczności zakonserwowania kosmetyku. Jest to znaczący zabieg, ale dużo zależy od konsumenta i tego jak on ten kosmetyk użytkuje – zaznacza Dorota Rożek.
– Skażenie mikrobiologiczne można podzielić na pierwotne i wtórne. Pierwotne powstaje na etapie linii produkcyjnej, mamy wówczas do czynienia ze skażeniem surowców, ich niedosuszeniem lub na przykład pojawieniem się pleśni. Skażenie wtórne następuje w momencie, gdy konsument niewłaściwie stosuje kosmetyk.
Co to znaczy? Chodzi o narażanie produktów na działanie promieni słonecznych, wysokich temperatur, niedomykanie i niedokręcanie opakowań. O nieodpowiednim sposobie użytkowania może świadczyć zmiana konsystencji, koloru czy nieprzyjemny zapach. Warto stać się świadomym konsumentem w każdej sytuacji, zarówno kupując artykuły spożywcze, jak i kosmetyczne.
Czytanie etykiet, czyli składu i zalecanego sposobu przechowywania, stosowania oraz przestrzeganie terminu ważności nie jest bez znaczenia. Podkreśla to każdy specjalista. Boimy się konserwantów, unikamy parabenów, a zapominamy o rzeczach podstawowych: zdrowym rozsądku i umiarze oraz własnej odpowiedzialności. Zepsuty kosmetyk może być szkodliwy! A parabeny? Kierownik laboratorium firmy Vipera Cosmetics podkreśla, że to nie jest takie proste, aby kosmetyk przeniknął przez skórę do krwiobiegu. Często nie można doprowadzić do przeniesienia substancji aktywnych w głąb skóry, z uwagi na to, że preparaty zazwyczaj zatrzymują się na etapie naskórka. Czy wobec tego warto nadal obawiać się konserwantów?
Konserwacja alternatywna
Kosmetyk bez konserwantów, nawet przechowywany w lodówce, miałby ważność kilka dni. A to, że on stoi rok czy dwa lata na półce sklepowej, a potem trafia do nas i jest użytkowany przez kolejny rok oznacza, że musi mieć dodane coś, co pozwala zachować trwałość receptury, czyli zakonserwować ją.
- Jeżeli nie parabeny, to inne środki konserwujące, ale zawsze jakiś konserwant musi być zastosowany. Wyjątkiem jest forma faktycznie wolna od konserwantu, bo sama w sobie jest trwała, czyli ma w składzie bardzo dużo alkoholu np. perfumy. Alkohol posiada właściwości konserwujące – tłumaczy Dorota Rożek.
Ekstrakty roślinne mogą być dobrym kierunkiem w zabezpieczaniu kosmetyków. Na razie jednak doświadczenia z ich zastosowaniem nie są wystarczające.
Najpierw należy udowodnić, że surowiec działa, musi przejść wymagane testy, które wykażą skuteczność w danej recepturze. Mówiąc o konserwantach naturalnych, należy wyjaśnić co rozumie się pod tym hasłem. Mając na myśli ekstrakty, często zapominamy, że ekstrahuje się różne związki chemiczne i w różny sposób, a przy tym jest to zabieg wymagający wiele wysiłku i czasu. Dla wielu technologów ekstrakty naturalne nie wykazują satysfakcjonującego działania Każdy składnik musi wykazać przede wszystkim swoją skuteczność, a konsumenci powinni zrozumieć, że to co syntetyczne nie musi być niezdrowe i złe.
Dorota Rożek zwraca uwagę, że również ekstrakt jest konserwowany. Powinniśmy zdać sobie sprawę, że to nie jest roślina w czystej postaci i rozpuszczalnik, bo przecież musi zawierać pewne dawki konserwantu. Pozostaje pytanie na ile jest to skuteczne i trwałe. Na rynku kosmetycznym co jakiś czas pojawiają się nowe substancje konserwujące. Nie działają one jednak tak wydajnie jak parabeny i aby całkowicie zabezpieczyć kosmetyk, technolog musi użyć dodatkowego wspomagacza. Istnieje firma, która szczyci się kosmetykami pozbawionymi syntetycznych składników, które należy przechowywać w lodówce, a ich data ważności to jedynie 2,5 miesiąca. Swoją trwałość mają zawdzięczać ekstraktowi z pestek grejpfruta i olejkowi różanemu.
– Rzeczywiście olejek grejpfrutowy ma działanie antybakteryjne, ale nie na tyle silne żeby zakonserwować gotowy krem – ocenia Monika Krzyżostan. Konserwanty mogą być zastąpione lub działać synergicznie m. in. z następującymi środkami w odpowiednim stężeniu:
- gliceryna >40%
- glikol propylenowy >15%
- metylopropandiol>20%
- glikol pentylenowy >5%
- heksandiol >4%
- caprylyl glycol >1%
Zastosowanie substancji naturalnych o właściwościach konserwujących daje możliwość tworzenia kosmetyków typu „bez konserwantów” (ang. preservative-free) oraz wyeliminowanie ze składu potencjalnego alergenu. Z drugiej strony jednak powoduje wzrost kosztów produkcji, doprowadza do bardzo częstej niezgodności z recepturą kosmetyku, a co najważniejsze nie gwarantuje pełnego zabezpieczenia czystości mikrobiologicznej.
Każdy z nas powinien zdecydować, czego oczekuje od produktu. Z opinii ekspertów wynika, że parabenów nie należy się obawiać, a moda na ich potępianie napędzana jest przez koncerny. Zarówno technologowie z firm produkujących kosmetyki kolorowe, ekologiczne, surowce kosmetyczne, jak i laborant przeprowadzający ocenę bezpieczeństwa produktu kosmetycznego uznali, że kosmetyki należy konserwować. Parabeny są znane od wielu lat, doskonale przebadane i przez wielu specjalistów uważane za bezpieczne.
Źródło: http://biotechnologia.pl/





















 Już 26 lutego rusza kampania Warto Kartą.
Już 26 lutego rusza kampania Warto Kartą.
 Myjesz się, złuszczasz martwy naskórek i używasz kosmetyków do ciała. Wszystko po to, żeby mieć piękną i gładką skórę. To wyjątkowy organ o skomplikowanej budowie. Stanowi narzędzie komunikacji między organizmem a środowiskiem zewnętrznym. Co więcej, dzięki zakończeniom nerwowym odbiera bodźce z otoczenia, a przez wydzielanie specyficznych substancji chemicznych, przekazuje informacje dla świata zewnętrznego.
Myjesz się, złuszczasz martwy naskórek i używasz kosmetyków do ciała. Wszystko po to, żeby mieć piękną i gładką skórę. To wyjątkowy organ o skomplikowanej budowie. Stanowi narzędzie komunikacji między organizmem a środowiskiem zewnętrznym. Co więcej, dzięki zakończeniom nerwowym odbiera bodźce z otoczenia, a przez wydzielanie specyficznych substancji chemicznych, przekazuje informacje dla świata zewnętrznego.

 Pigułka „dzień po” już niebawem będzie dostępna bez recepty. Jaka jest jej skuteczność? Czy jest bezpieczna? I czy nie jest to czasem środek wczesnoporonny? Czas na odpowiedzi!
Pigułka „dzień po” już niebawem będzie dostępna bez recepty. Jaka jest jej skuteczność? Czy jest bezpieczna? I czy nie jest to czasem środek wczesnoporonny? Czas na odpowiedzi!
 Na opakowaniach produktów kosmetycznych pojawiły się napisy 0% parabenów albo paraben free. Czy wobec tego są one szkodliwe i należy ich unikać choć latami stosowane były przez firmy farmaceutyczne, kosmetyczne oraz producentów żywności? Produkt wolny od parabenów nadal ma długą datę ważności, czym zatem tego został zakonserwowany? Ekstraktem roślinnym czy może chemią pod inną nazwą?
Na opakowaniach produktów kosmetycznych pojawiły się napisy 0% parabenów albo paraben free. Czy wobec tego są one szkodliwe i należy ich unikać choć latami stosowane były przez firmy farmaceutyczne, kosmetyczne oraz producentów żywności? Produkt wolny od parabenów nadal ma długą datę ważności, czym zatem tego został zakonserwowany? Ekstraktem roślinnym czy może chemią pod inną nazwą? Poza brakiem jednoznacznych wyników badań, wskazujących na jakikolwiek szkodliwy wpływ parabenów na zdrowie człowieka, technologowie podkreślają jego właściwości dla spójności kosmetyków. Niektóre konserwanty bardzo rozrzedzają masę, z reguły dodaje się je na koniec recepturowania, po dodaniu składników aktywnych w temperaturze pokojowej. Parabeny nie mają wpływu na konsystencję, tak więc z technologicznego punktu widzenia są łatwe we wprowadzaniu do receptur. Jednak z biznesowej strony, warto było wykreować kosmetyczną burzę, która na pewno zapewniła branży niemałe profity. Scientific Committee on Consumer Safety (SCCS) wydał opinię na temat analizowanych konserwantów. Stwierdzono, że zastosowanie maksymalnego dopuszczonego stężenia methylparabenu i ethylparabenu uznaje się za bezpieczne. Poza tym, wykorzystywanie butylparabenu i propylparabenu w finalnym wyrobie kosmetycznym jest niegroźne dla konsumenta w koncentracji 0,19%. Wnioski zostały wyciągnięte w oparciu o badania wykonywane na szczurach. Wykazano brak danych naukowych decydujących o zależności pomiędzy wchłanianiem przez skórę zwierzęcia i człowieka, ze szczególnym uwzględnieniem metabolizmu macierzystego związku chemicznego w skórze.
Poza brakiem jednoznacznych wyników badań, wskazujących na jakikolwiek szkodliwy wpływ parabenów na zdrowie człowieka, technologowie podkreślają jego właściwości dla spójności kosmetyków. Niektóre konserwanty bardzo rozrzedzają masę, z reguły dodaje się je na koniec recepturowania, po dodaniu składników aktywnych w temperaturze pokojowej. Parabeny nie mają wpływu na konsystencję, tak więc z technologicznego punktu widzenia są łatwe we wprowadzaniu do receptur. Jednak z biznesowej strony, warto było wykreować kosmetyczną burzę, która na pewno zapewniła branży niemałe profity. Scientific Committee on Consumer Safety (SCCS) wydał opinię na temat analizowanych konserwantów. Stwierdzono, że zastosowanie maksymalnego dopuszczonego stężenia methylparabenu i ethylparabenu uznaje się za bezpieczne. Poza tym, wykorzystywanie butylparabenu i propylparabenu w finalnym wyrobie kosmetycznym jest niegroźne dla konsumenta w koncentracji 0,19%. Wnioski zostały wyciągnięte w oparciu o badania wykonywane na szczurach. Wykazano brak danych naukowych decydujących o zależności pomiędzy wchłanianiem przez skórę zwierzęcia i człowieka, ze szczególnym uwzględnieniem metabolizmu macierzystego związku chemicznego w skórze.
- Oczywiście wykonuje się testy konserwacji, czyli badania skuteczności zakonserwowania kosmetyku. Jest to znaczący zabieg, ale dużo zależy od konsumenta i tego jak on ten kosmetyk użytkuje – zaznacza Dorota Rożek.
- Oczywiście wykonuje się testy konserwacji, czyli badania skuteczności zakonserwowania kosmetyku. Jest to znaczący zabieg, ale dużo zależy od konsumenta i tego jak on ten kosmetyk użytkuje – zaznacza Dorota Rożek.
 W ostatnim czasie modne stało się stosowanie kwasów. Stosuje się je w różnej postaci, albo pojedynczo w rożnym stężeniu, albo połączenie kilku kwasów. Kwasy są też dodawane do kremów, w niewielkim stężeniu, w celu stopniowego złuszczania naskórka i poprawy struktury i wyglądu skóry.
W ostatnim czasie modne stało się stosowanie kwasów. Stosuje się je w różnej postaci, albo pojedynczo w rożnym stężeniu, albo połączenie kilku kwasów. Kwasy są też dodawane do kremów, w niewielkim stężeniu, w celu stopniowego złuszczania naskórka i poprawy struktury i wyglądu skóry.
 Jakby bocznymi drzwiami, do świata kosmetyki wkroczyły blogerki. Najpierw hobbystycznie, teraz już niemal zarobkowo – opisują kosmetyki, zabiegi, a ostatnio nawet całe obiekty. Na czym polega fenomen rosnącej popularności blogów? Czy warto z nimi współpracować, żeby zwiększyć swoje szanse sprzedaży?
Jakby bocznymi drzwiami, do świata kosmetyki wkroczyły blogerki. Najpierw hobbystycznie, teraz już niemal zarobkowo – opisują kosmetyki, zabiegi, a ostatnio nawet całe obiekty. Na czym polega fenomen rosnącej popularności blogów? Czy warto z nimi współpracować, żeby zwiększyć swoje szanse sprzedaży?
 Swoją wielką popularność zdobył dopiero w latach 70. ubiegłego wieku. Dzisiaj należy do jednych z najczęściej unowocześnianych produktów do makijażu. Od pierwotnego założenia przeszedł bowiem kolosalne transformacje. Nabrał kolorów, smaków, zapachów, a nawet długotrwałych efektów. Znany i ceniony przez tysiące kobiet na całym świecie, błyszczyk na nowo podbija rynek kosmetyczny
Swoją wielką popularność zdobył dopiero w latach 70. ubiegłego wieku. Dzisiaj należy do jednych z najczęściej unowocześnianych produktów do makijażu. Od pierwotnego założenia przeszedł bowiem kolosalne transformacje. Nabrał kolorów, smaków, zapachów, a nawet długotrwałych efektów. Znany i ceniony przez tysiące kobiet na całym świecie, błyszczyk na nowo podbija rynek kosmetyczny
 Surowce mineralne w błyszczykach
Surowce mineralne w błyszczykach
 Jak wykorzystać produkty, które znajdują się w każdym domu?
Jak wykorzystać produkty, które znajdują się w każdym domu?